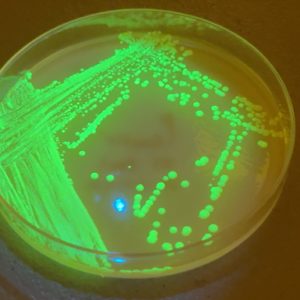

¿Puede una cerveza funcionar como vacuna? Esa es la provocadora pregunta que planteó el virólogo Christopher Buck, investigador del National Cancer Institute de Estados Unidos, tras elaborar y beber una cerveza casera que contiene levaduras modificadas para producir proteínas del BK polyomavirus. En un experimento de autoensayo que ha generado fascinación y controversia, Buck reportó que su organismo produjo anticuerpos contra el virus después de beber varias tandas del brebaje. La historia —recogida por medios como Smithsonian Magazine, Science News y Reason— abre un debate científico y ético sobre las vacunas comestibles, el uso de levaduras como plataformas biotecnológicas y los límites entre la innovación experimental y la regulación sanitaria.
ChileBio / 15 de marzo, 2026.- La idea suena a ciencia ficción, a biohacking extremo o a una provocación deliberada: un virólogo prepara en su casa una cerveza hecha con levaduras modificadas genéticamente, la bebe durante varios días y luego muestra en su sangre señales de respuesta inmune contra un virus humano potencialmente peligroso. Esta no es una escena de película, sino que fue exactamente lo que hizo Christopher Buck, investigador del National Cancer Institute de Estados Unidos, en un experimento que ha desatado fascinación, críticas éticas y una discusión seria sobre hasta dónde podría llegar el concepto de las «vacunas comestibles».
Buck no es un aficionado improvisado. En su trabajo formal estudia polyomavirus humanos y se le atribuye el descubrimiento de cuatro de los 13 polyomavirus conocidos que infectan a humanos. Su objetivo de fondo es combatir el BK polyomavirus, un virus muy común que suele pasar desapercibido en personas sanas, pero que puede reactivarse en pacientes inmunosuprimidos —como quienes reciben trasplantes— y provocar complicaciones graves, incluyendo inflamación, daño orgánico y falla del injerto. Un reportaje de la Smithsonian Magazine resume además que el virus puede estar asociado a enfermedades renales, vesicales, cerebrales y cardiovasculares, mientras que otro reportaje de Reason recuerda que alrededor del 90% de las personas ya tienen anticuerpos contra este virus hacia los 10 años de edad.
[Recomendado: Vacuna comestible contra el cólera obtenida en arroz transgénico pasa con éxito ensayo clínico Fase 1]
De un laboratorio formal a una cocina con fermentador
El punto de partida no fue la cerveza, sino una línea de investigación convencional. Según Science News, el grupo de Buck ya trabajaba en una vacuna inyectable contra polyomavirus, basada en la proteína de la cápside viral VP1, producida en células de insecto para formar partículas similares al virus (VLPs) pero vacías, sin capacidad de causar infección. En monos rhesus, esa formulación había mostrado respuestas de anticuerpos muy altas y duraderas durante cerca de dos años. Fue entonces cuando Buck empezó a preguntarse si realmente hacía falta purificar esas partículas y aplicarlas por inyección.
Su solución fue usar Saccharomyces cerevisiae, la levadura de pan y cerveza. Modificó esta levadura para que fabricara la proteína de la cubierta del virus y luego la incorporó en una receta de cerveza de trigo. Buck cuenta que utilizó un kit Flash Hefeweizen y un té de lúpulo preparado con pellets Saphir. Smithsonian, por su parte, subraya que Buck llevaba 30 años elaborando cerveza casera, y que cuando vio que en ratones funcionaba la alimentación con levaduras vivas modificadas, pensó de inmediato: “Bueno, definitivamente puedo hacerlo en casa”, según escribió en un post citado por ese medio.

¿Por qué una cerveza podría funcionar como vacuna?
La lógica biológica es más seria de lo que el formato sugiere. En experimentos previos, Buck y colegas alimentaron ratones con levaduras vivas que contenían partículas semejantes al BK polyomavirus. Para su sorpresa, los animales produjeron anticuerpos contra el virus. Smithsonian explica que el equipo interpreta que la levadura viva podría proteger a las proteínas virales del ácido del estómago, permitiendo que lleguen al intestino, donde el sistema inmune puede reconocerlas y montar una respuesta.
“La idea consiste simplemente en tomar levadura viva, que es lo que hace que se elabore la cerveza, e introducir una vacuna en su interior. De esta forma, se consigue que la levadura genere una respuesta inmunitaria”, afirma Buck en el reportaje de Smithsonian. En la misma intervención agregó que se trataría de “un enfoque radicalmente simplificado para fabricar vacunas”.
La idea, por tanto, no es que la cerveza tenga magia inmunológica, sino que la levadura funciona como vehículo biológico y alimentario para transportar un antígeno viral hasta el sistema inmune intestinal. Buck ve en esto un modelo de vacunas comestibles futuras, no necesariamente limitadas a cerveza.
El autoensayo: pintas, refuerzos y anticuerpos
Aquí es donde el relato se vuelve más polémico. Los reportajes de Smithsonian y Science News informan que Buck tomó una pinta diaria (alrededor de medio litro) de cerveza durante cinco días en mayo, luego un refuerzo de otros cinco días siete semanas después, y otro más siete semanas más tarde. Hubo varias rondas de consumo del brebaje, seguidas por análisis de sangre periódicos.
Lo importante es el desenlace: Buck reportó que su organismo generó anticuerpos contra varios tipos del BK polyomavirus tras beber la cerveza. Science News entrega el mayor detalle: antes del experimento ya tenía anticuerpos contra uno de los cuatro subtipos, pero tras beber la cerveza vio subir los niveles contra BK tipo IV y, aún más rápido, contra BK tipo II. De acuerdo con ese medio, los anticuerpos contra los subtipos I y II alcanzaron el umbral considerado protector para pacientes trasplantados, mientras que los de tipo IV no llegaron a ese nivel. Smithsonian resume el hallazgo señalando que los análisis de sangre sugirieron anticuerpos frente a dos tipos de BK polyomavirus que se cree están implicados en algunos cánceres de vejiga.
Buck también dijo que no notó efectos adversos significativos. En Science News se menciona que él, su hermano Andrew y otros familiares consumieron la cerveza “sin efectos adversos”, aunque ese mismo medio aclara que no hay resultados sanguíneos del hermano ni de los otros familiares.
Y sí, a Buck le gustó el producto. La frase se repite en varios medios y terminó siendo una de las más recordadas del caso: “Fue una de las mejores cervezas caseras que he hecho”, dijo, según Reason, Smithsonian y The Times.
El costado más ambicioso: ¿vacunas en cerveza, yogur o chips?
Buck no ve esta experiencia como una rareza aislada, sino como una demostración de principio. Smithsonian cita una frase suya: “Esta vacuna solo está demostrando el principio”. Y enseguida expone su ambición: “Lo siguiente en la agenda son el Covid y la gripe, y probablemente los herpesvirus y el adenovirus… Cualquier virus que cause un resfriado común está ahora en nuestro punto de mira”.
Buck quiere que el método quede publicado para que otros también puedan reproducirlo, y presenta su argumento político-regulatorio: según él, la gente debería tener derecho a «vacunas caseras» para evitar procesos regulatorios demasiado lentos. En ese marco, sostiene que si los alimentos elaborados con esa levadura no se venden como terapias, no necesariamente entrarían bajo la misma regulación que una vacuna farmacéutica tradicional, especialmente si sus componentes ya están dentro del suministro alimentario y son considerados «generalmente considerado seguro» (“generally regarded as safe” o GRAS), bajo el sistema regulatorio estadounidense.
Buck sugirió que la levadura modificada podría usarse no solo en cerveza, sino también en yogur o “crisps”. Science News menciona además que está experimentando con chips de levadura seca o cápsulas, aunque todavía no cuenta con infraestructura de manufactura a gran escala.

El choque con la burocracia y la creación de “Gusteau Research Corporation”
Parte importante de esta innovación de «vacuna casera» gira en torno al conflicto institucional. Science News cuenta que un comité de ética de los National Institutes of Health le dijo a Buck que no podía experimentar consigo mismo bebiendo la cerveza. Buck respondió que esa autoridad podía regular lo que hacía en su trabajo, pero no lo que hacía en su vida privada. Para marcar esa frontera creó una organización sin fines de lucro llamada Gusteau Research Corporation, de la que es el único empleado. El nombre viene del chef Auguste Gusteau, de Ratatouille, cuyo lema era “Cualquiera puede cocinar”. Reason y Smithsonian repiten esa historia, y agregan que el hermano de Buck fundó Remy LLC, también inspirada en la película.
Science News reportó además que un segundo comité ético del NIH objetó que Buck subiera los manuscritos a bioRxiv por incluir autoexperimentación. Buck respondió con dureza: “La burocracia está frenando la ciencia, y eso me resulta inaceptable”. Ese mismo medio informó que el 4 de febrero de 2026 fue notificado de que quedaba en licencia administrativa remunerada mientras se investigaba el caso.
Reason aprovecha este conflicto para enmarcar a Buck dentro de una tradición de autoexperimentadores en vacunas, junto con Charles Nicolle, Jonas Salk y Albert Sabin; incluso recuerda el caso del grupo Rapid Deployment Vaccine Collaborative, que al inicio de la pandemia de COVID-19 desarrolló y se administró una vacuna nasal DIY antes de que existieran vacunas comerciales disponibles.
Las críticas: seguridad, eficacia y confianza pública
Hasta aquí, la historia puede leerse como una mezcla de ingenio biotecnológico, rebeldía regulatoria y fervor científico. Pero ninguno de los reportajes citados la presenta como una validación clínica. Enfatizan que lo reportado es preliminar, que los manuscritos fueron subidos a Zenodo en diciembre y que no han sido revisados por pares. Smithsonian lo deja claro desde el inicio y subraya que, antes de que algo así pudiera convertirse en una vacuna disponible, harían falta muchas más pruebas de seguridad y eficacia.
Science News plantea la advertencia de forma más explícita: aunque Buck mostró anticuerpos en sí mismo, eso no garantiza que otras personas respondan igual, y las vacunas normalmente se prueban en grupos mucho más grandes para evaluar eficacia real y detectar efectos secundarios inesperados.
Smithsonian destaca a dos voces críticas. El virólogo Michael Imperiale, de la University of Michigan Medical School, quien dijo a Science News que la estrategia necesitaría mucho más testeo de seguridad y eficacia, y que ni siquiera estaba claro qué posibles efectos adversos estaban buscando Buck y sus colegas. El bioeticista Arthur Caplan, de la NYU Grossman School of Medicine, también citado por Science News y recogido por Smithsonian, fue todavía más directo: “Este no es el lugar para que-lo-haga-usted-mismo”. Caplan teme que algo así pueda agravar la desconfianza hacia las vacunas en un contexto ya cargado de sentimiento antivacunas.
Reason, en cambio, pone más peso en el argumento libertario del propio Buck. Allí él sostiene que las vacunas han salvado 154 millones de vidas desde 1974 y que, en un contexto donde algunos sectores políticos intentan restringir el acceso a vacunas tradicionales, las vacunas basadas en alimentos podrían devolver “autoridad autónoma para la toma de decisiones” a las personas. Es una lectura mucho más ideológica del caso que la de Smithsonian, que prefiere el ángulo de curiosidad científica con fuertes cautelas médicas.
[Recomendado: Italia e Israel cultivan microalgas transgénicas para desarrollar una vacuna comestible contra COVID19]
Lo que realmente está en juego
Más allá del impacto mediático del término “cerveza-vacuna”, el experimento de Buck toca varios temas profundos a la vez: la posibilidad de vacunas mucosales u orales más baratas y fáciles de distribuir, el uso de levaduras modificadas como plataformas biotecnológicas, la tensión entre innovación individual y regulación sanitaria, y el problema de cómo comunicar resultados prometedores sin transformarlos en una invitación prematura al “hazlo tú mismo”.
Buck, por su parte, no ha rebajado su tono. En Science News dijo que este es “el trabajo más importante de toda mi carrera” y que es “lo suficientemente importante como para arriesgar mi carrera por ello”. Esa mezcla de convicción científica, desafío institucional y teatralidad mediática explica por qué su cerveza-vacuna ha capturado tanta atención.
¿Estamos viendo el embrión de una nueva generación de vacunas comestibles? ¿O un caso de autoexperimentación tan seductor como científicamente insuficiente en términos clínicos y regulatorios? Por ahora, la respuesta honesta es que todavía no lo sabemos.
Lo que sí está claro es que Christopher Buck convirtió una pregunta improbable —si una cerveza podría servir como vacuna— en un experimento real, medible y polémico. Smithsonian lo presenta como una idea audaz que “parece haber funcionado”, aunque solo de manera preliminar. Reason lo enmarca como una vía para esquivar un sistema regulatorio lento. Y Science News lo usa como ventana para discutir los límites éticos, legales y científicos del desarrollo de vacunas.
La historia deja una lección especialmente interesante: la biotecnología no siempre avanza en línea recta, ni solo desde grandes farmacéuticas o ensayos clínicos perfectos. A veces también avanza desde ideas extravagantes que obligan a la ciencia a responder una pregunta incómoda pero fascinante: si un alimento puede enseñar al sistema inmune a defenderse, ¿Cómo debería estudiarse, regularse y contarse esa posibilidad?

